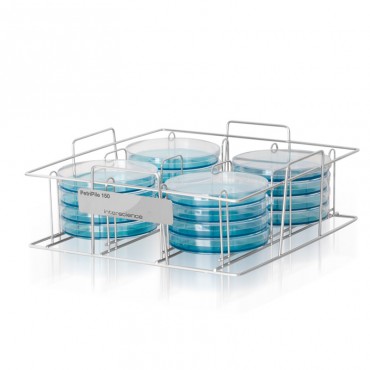

BagRack
CAD$350.07
Microbiology equipment
FILTER BY
Categories

Innovation Diagnostics is focused on improving Microbiology lab efficiencies and productivity by automating tedious tasks and processes.
This section is filled with innovative tools ranging from culture media preparation, automatic agar filling, tube filling, colony counting, sample dilution and much more.
There are 7 products.
Sort by: